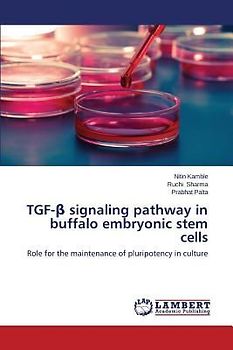

Gebrauchte Bücher von Sharma, Ruchi bei rebuy
… Von Expert:innen geprüfte Sharma, Ruchi-Bücher. Entdecke unsere Riesenauswahl und bestelle ohne Risiko. Nachhaltig und günstig!
… Von Expert:innen geprüfte Sharma, Ruchi-Bücher. Entdecke unsere Riesenauswahl und bestelle ohne Risiko. Nachhaltig und günstig!

TGF-¿ signaling pathway in buffalo embryonic stem cells
Nur als Neuware

INFECTION DE LA CAVITÉ BUCCALE, DE LA TÊTE ET DU COU
Nur als Neuware

How Disabled Friendly is Transport System in Indian Cities

Muffin enrichi de graines de papaye et d'avoine pour la santé et le bien-être

Muffin arricchiti di semi di papaya e avena per la salute e il benessere

Mit Papayasamen und Hafer angereicherter Muffin für Gesundheit und Wohlbefinden

Papaya Seed and Oat Fortified Muffin for Health and Wellness

Effect of Auxins on Rooting, Growth and Flowering of African Marigold

INFECTION IN ORAL CAVITY , HEAD AND NECK REGION

INFEZIONE NELLA CAVITÀ ORALE, NELLA REGIONE DELLA TESTA E DEL COLLO

INFEKTIONEN IN DER MUNDHÖHLE, IM KOPF- UND HALSBEREICH

Efecto de las auxinas en el enraizamiento, el crecimiento y la floración de la caléndula africana

INFECCIÓN EN LA CAVIDAD BUCAL, EN LA REGIÓN DE LA CABEZA Y EL CUELLO

Muffin fortificado con semillas de papaya y avena para la salud y el bienestar
Lieber Geld verdienen als ausgeben?
Verkauf Elektronik und Medien ganz einfach an uns
Versand immer kostenlos und versichert 100 % Löschung deiner Daten Erfahrung und Sicherheit seit 2004
Der Streichpreis bezieht sich auf die unverbindliche Preisempfehlung des Herstellers, den aktuellen durchschnittlichen Neupreis des Produktes bei idealo Deutschland, oder bei Büchern auf den festgelegten Preis für Neuware.
